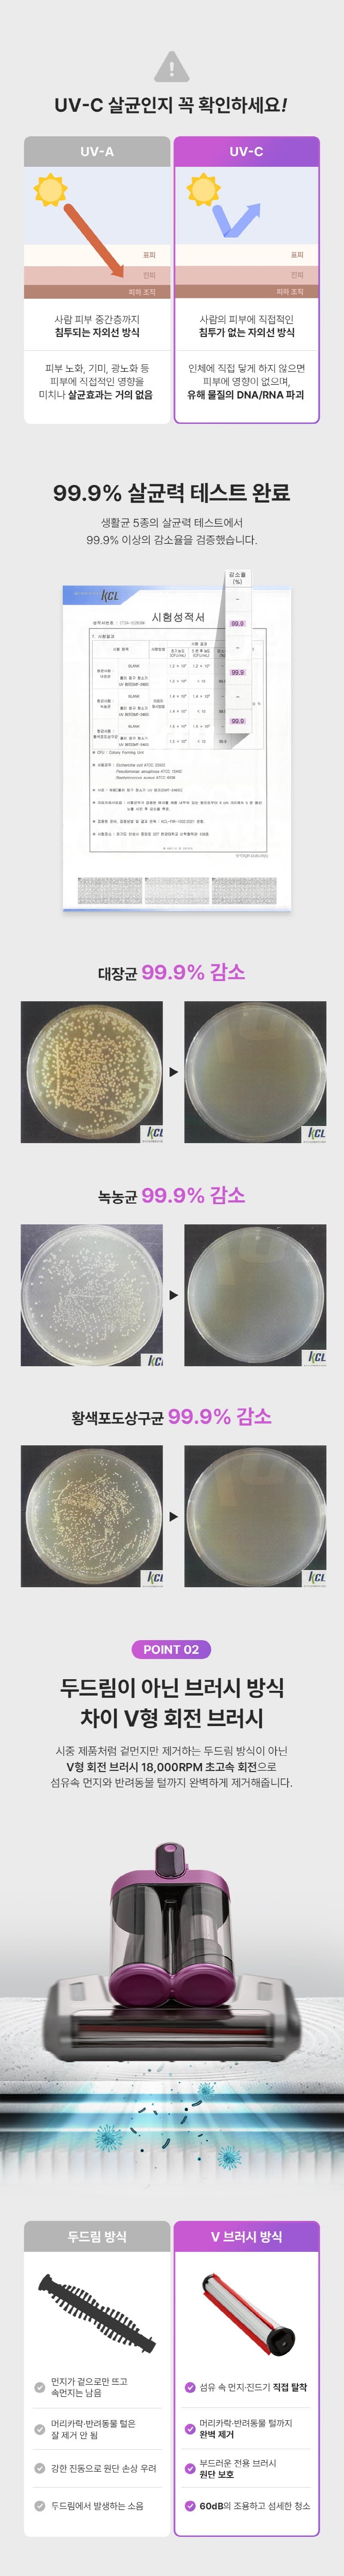

- 홈인테리어
- 건강/다이어트
- 뷰티/위생용품
- 식품·간편식
- 생활/애완용품
- 주방용품
- 주방가전
- 생활가전
- 자동차·스포츠
- 출산·유아동
- 패션/잡화
- 도서/완구/사무
- 여행/캠핑
- -------------------
- AD랑 프리미엄 할부
- 7 Day 나눔 보너스
- AD랑 나눔 기부
- AD랑 SP 공유
- -------------------
- 정회원 전용 온라인 스토어
- VIP 전용 온라인 스토어
- VVIP 전용 온라인 스토어
- 플래티넘 전용 온라인 스토어
- BCP 전용 온라인 스토어
- RP 전용 온라인 스토어
- -------------------
- AD랑 정기구독 (e랑pay 전용)
- -------------------
- GT# (정기구독&쿠폰)
- GT# 오픈마켓
- GT랑
- -------------------
- P2P
- B2B
- B2C 전용마켓
- -------------------